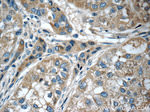
SERPINA6 Antibody in Immunohistochemistry (Paraffin) (IHC (P))
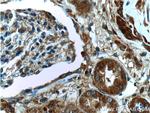
SERPINA6 Antibody in Immunohistochemistry (Paraffin) (IHC (P))

Search
Proteintech
SERPINA6 Polyclonal Antibody
{{$productOrderCtrl.translations['antibody.pdp.commerceCard.promotion.promotions']}}
{{$productOrderCtrl.translations['antibody.pdp.commerceCard.promotion.viewpromo']}}
{{$productOrderCtrl.translations['antibody.pdp.commerceCard.promotion.promocode']}}: {{promo.promoCode}} {{promo.promoTitle}} {{promo.promoDescription}}. {{$productOrderCtrl.translations['antibody.pdp.commerceCard.promotion.learnmore']}}
产品信息
12010-1-AP
种属反应
已发表种属
宿主/亚型
分类
类型
抗原
偶联物
形式
浓度
规格
纯化类型
保存液
内含物
保存条件
运输条件
产品详细信息
Immunogen sequence: QAMDPNAAY VNMSNHHRGL ASANVDFAFS LYKHLVALSP KKNIFISPVS ISMALAMLSL GTCGHTRAQL LQGLGFNLTE RSETEIHQGF QHLHQLFAKS DTSLEMTMGN ALFLDGSLEL LESFSADIKH YYESEVLAMN FQDWATASRQ INSYVKNKTQ GKIVDLFSGL DSPAILVLVN YIFFKGTWTQ PFDLASTREE NFYVDETTVV KVPMMLQSST ISYLHDAELP CQLVQMNYVG NGTVFFILPD KGKMNTVIAA LSRDTINRWS AGLTSSQVDL YIPKVTISGV YDLGDVLEEM GIADLFTNQA NFSRITQDAQ LKSSKVVHKA VLQLNEEGVD TAGSTGVTLN LTSKPIILRF NQPFIIMIFD HFTWSSLFLA RVMNPV (21-406 aa encoded by BC058021)
靶标信息
This gene encodes an alpha-globulin protein with corticosteroid-binding properties. This is the major transport protein for glucorticoids and progestins in the blood of most vertebrates. The gene localizes to a chromosomal region containing several closely related serine protease inhibitors which may have evolved by duplication events.
仅用于科研。不用于诊断过程。未经明确授权不得转售。
生物信息学
蛋白别名: CBG; corticosteroid binding globulin precursor; Corticosteroid-binding globulin; serine (or cysteine) proteinase inhibitor, clade A (alpha-1 antiproteinase, antitrypsin), member 6; Serpin A6; serpin peptidase inhibitor, clade A (alpha-1 antiproteinase, antitrypsin), member 6; Transcortin; unnamed protein product
基因别名: CBG; SERPINA6
UniProt ID: (Human) P08185
Entrez Gene ID: (Human) 866